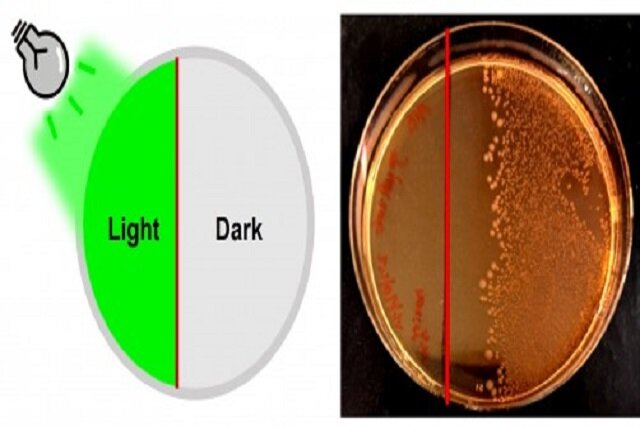

به گزارش ایسنا، پنیسیلین و دیگر آنتیبیوتیکها از ابزارهای اصلی پزشکان برای درمان عفونتهای باکتریاییاند. اما مشکلی که وجود دارد این است که بخشی از این داروها در بدن مصرف نمیشود و وارد فاضلاب میگردد؛ جایی که میتواند منجر به شکلگیری باکتریهای مقاوم به دارو شود. این پدیده نگرانی بزرگی در سلامت عمومی ایجاد کرده و باعث شده بسیاری از درمانها در آینده اثرگذاری کمتری داشته باشند.
پژوهش در زمینه کنترل دقیق فعالیت داروها یکی از راههای پیشنهادی برای حل این مشکل است. اگر بتوان دارو را در زمان و مکان خاصی فعال کرد، هم اثربخشی آن بیشتر میشود و هم احتمال بروز مقاومت باکتریایی کاهش مییابد. بهویژه در عفونتهای موضعی، چنین راهکاری میتواند از آسیب به سایر بخشهای بدن جلوگیری کند. به همین دلیل، دانشمندان به دنبال ساخت آنتیبیوتیکهایی هستند که فقط در صورت نیاز و در محل عفونت فعال شوند.
در همین راستا، تیمی پژوهشی از مراکز تحقیقاتی هلند و آلمان با محوریت دانشگاه گرونینگن، پژوهشی را انجام دادهاند. این تیم، نوعی آنتیبیوتیک جدید را معرفی کردهاند که تنها با نور سبز فعال میشود. آنها پنیسیلین را به گونهای تغییر دادند که تا زمانی که با نور سبز مواجه نشود، غیرفعال باقی بماند.
در این روش، یک مولکول حساس به نور به پنیسیلین متصل میشود. این مولکول همانند یک قفل عمل میکند و اجازه نمیدهد دارو در بدن فعال شود. اما وقتی نور سبز به آن تابیده میشود، این مولکول جدا شده و دارو فعال میگردد. چنین سیستمی باعث میشود که پزشکان بتوانند کنترل دقیقی بر محل و زمان فعالسازی دارو داشته باشند.
نتایج اولیه این تحقیق بسیار امیدوارکننده بودهاند. در محیط آزمایشگاهی، این داروی نوری توانست رشد باکتری E. coli و تشکیل لایه محافظتی باکتری Staphylococcus epidermidis را مهار کند. این دو باکتری از عوامل رایج عفونت هستند و مهار آنها با چنین دقتی، بسیار مهم است.
در ادامه، محققان این دارو را روی لاروهای آلوده نوعی حشره آزمایش کردند که از نظر عملکرد ایمنی شباهت زیادی به انسان دارد. درمان با این پنیسیلین نوری، همراه با تابش نور سبز، باعث شد نرخ بقای لاروها از ۳۰ درصد به ۶۰ درصد افزایش یابد. این موضوع نشان میدهد که روش فوق نهتنها در آزمایشگاه، بلکه در موجود زنده هم کارآمد است.
بر اساس این یافتهها، میتوان از نور به عنوان ابزاری برای هدایت و فعالسازی داروها استفاده کرد. اگرچه هنوز راه زیادی برای آزمایش روی انسان باقی مانده، اما این گام اولیه میتواند به درمانهای دقیقتر، کمخطرتر و هدفمندتر منجر شود. همچنین احتمال استفاده از رنگهای مختلف نور برای کنترل همزمان چند دارو، ایدهای است که محققان در آینده پیگیری خواهند کرد.
نتایج این پژوهش در نشریه علمی ACS Central Science که نشریهای وابسته به انجمن شیمی آمریکا است و به چاپ پژوهشهای نوآورانه در حوزههای میانرشتهای میپردازد، منتشر شده اند.
انتهای پیام

نظرات